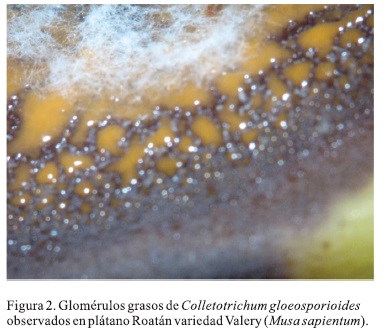

Servicios Personalizados
Revista
Articulo
Indicadores
-
 Citado por SciELO
Citado por SciELO -
 Accesos
Accesos
Links relacionados
-
 Similares en
SciELO
Similares en
SciELO
Compartir
Revista mexicana de micología
versión impresa ISSN 0187-3180
Rev. Mex. Mic vol.38 Xalapa dic. 2013
Contribuciones
Composición química de glomérulos producidos por Colletotrichum gloeosporioides
Chemical composition of glomeruli produced by Colletotrichum gloeosporioides
Olivia Márquez-Fernández1, Minerva Cano1, Alejandro Salinas1, Oswaldo Guzmán-López2, César Espinoza1, Ángel Trigos1
1 Laboratorio de Alta Tecnología de Xalapa, Universidad Veracruzana. Calle Médicos, 5, Col. Unidad del Bosque. CP. 91010, Xalapa, Veracruz, México.
2 Facultad de Ciencias Químicas, Universidad Veracruzana, Avenida Universidad Km 7.5 Coatzacoalcos, Veracruz, México.
* Autor para correspondencia:
Ángel Trigos atrigos@uv.mx
Recibido 10 de diciembre 2012;
Aceptado 12 de diciembre 2013.
Abstract
It is a well known fact that Colletotrichum gloeosporioides is a phytopathogenic fungus that affects various crops in all types of climates; it is known as the causative agent of antracnosis. On the other hand, it has been observed that, unlike other phytopathogenic species, this one produces glomeruli of fatty nature. However, although there are many reports in the literature regarding fitotoxic metabolites of various species of Colletotrichun, relatively no relevance has been given to a massive production of fatty acids using members of this genus when compared to other phytopathogenic fungi. Based on this fact, the aim of this paper was to characterize the chemical nature of the glomeruli which were found to be made up of palmitic, oleic, estearic and Iinoleic acids in the proportions of 40.1, 35.2, 18.8 and 5.9% respectively. This conclusion was reached conducting spectroscopic techniques such as nuclear magnetic resonance and mass spectrometry. Finally, the high production of fatty acids obtained in vitro as well as on fruiting bodies by C. gloeosporíoides opens the possibility of a better understanding about how this species is able to produce massive amounts of fatty acids as a possible non-selective strategy of invasion and penetration or as a mere evolutive characteristic of the genus which may be useful for its identification in the field.
Key words: fatty acids, fatty glomeruli.
Resumen
Es bien sabido que Colletotrichum gloeosporioides es un hongo fitopatógeno que afecta a diversos cultivos, en casi todos los climas; a éste se le reconoce como el agente causal de la antracnosis. Por otro lado, se ha observado que, a diferencia de otras especies fitopatógenas produce glomérulos de aspecto graso. Sin embargo, aunque se tienen numerosos reportes en la literatura acerca de los metabolites fitotóxicos de diversas especies de Colletotrichum, no se ha contemplado la importancia de la producción masiva de ácidos grasos por miembros de este género en comparación con otros hongos fitopatógenos; debido a ello, el objetivo de este trabajo fue caracterizar la naturaleza química de los glomérulos, encontrando que están constituidos de los ácidos palmítico, oleico, esteárico y linoléico, en una proporción de 40.1,35.2,18.8 y 5.9%, respectivamente. Esta identificación se llevó a cabo a través de técnicas espectroscópicas de resonancia magnética nuclear y espectrometría de masas. Finalmente, la producción elevada de ácidos grasos in vitro, así como en el fruto por C. gloeosporioides abre la posibilidad de que esta especie sea capaz de producir masivamente ácidos grasos como estrategia no selectiva de invasión y penetración o simplemente como una característica evolutiva del género que puede ser de utilidad para su identificación en campo.
Palabras clave: ácidos grasos, glomérulos grasos.
Introducción
El género Colletotrichum engloba varias especies que provocan enfermedades en una amplia variedad de cultivos, en casi todos los climas; éste es reconocido como el agente causal de la antracnosis, enfermedad que puede atacar cualquier parte de la planta (Jeffries et al., 1990). La antracnosis es una de las principales enfermedades postcosecha del banano que afecta la calidad de la fruta. La infección a los frutos se da normalmente durante su desarrollo en el campo, quedando latente hasta la madurez de los mismos, por lo que los síntomas se manifiestan generalmente durante su almacenamiento y muchas veces hasta la venta, trayendo consigo pérdidas económicas importantes. Los síntomas se presentan como lesiones ovaladas, oscuras y hundidas, con presencia de acérvulos de color naranja (Raut y Ranade, 2004).
Se considera que C. gloeosporioides es el agente causal de la antracnosis en cultivos de plátano, con base en su especificidad por el hospedero (Peres et al., 2002, Lima et al., 2003, Jeger et al., 1995). Las especies del género Colletotrichum, son conocidas por producir sustancias fitotóxicas de bajo peso molecular y enzimas que les confieren el carácter patogénico produciendo daños en diversos cultivos (Gohbara et al., 1978; Trigos et al., 1997; Jayasankar et al., 1999; García-Pajón y Collado, 2003); in vitro pueden producir metabolitos con propiedades fitotóxicas, que generalmente no son selectivos hacia el hospedero, ya que al ser ensayados en varios cultivos provocan síntomas similares a los causados por el hongo in vivo (Jayashinghe y Fernando, 2000). En este sentido, se ha encontrado que algunas especies de hongos fitopatógenos son capaces de producir metabolitos derivados de los lípidos (oxilipinas), más específicamente a partir de ácidos grasos insaturados, los cuales son capaces de regular el desarrollo, la producción de toxinas y de mediar la comunicación huésped-patógeno a fin de explotar los recursos de la planta para su crecimiento y desarrollo (Noverr et al., 2003; La Camera et al., 2004, Singh y Del Poeta, 2011). Sin embargo, aunque se tienen numerosos reportes en la literatura acerca de los metabolitos fitotóxicos de diversas especies de Colletotrichum, aún no se ha contemplado la importancia de la producción masiva de ácidos grasos por miembros de este género, en comparación con otros hongos fitopatógenos; debido a ello, el objetivo de este trabajo fue caracterizar la naturaleza química de los glomérulos producidos por C. gloeosporioides en medios de cultivo sólido y en frutos.
Materiales y métodos
Material biológico
La cepa de C. gloeosporioides (Penz.) Penz. & Sacc. utilizada para este estudio, fue donada por la Dra. María de Jesús Yañez Morales del Instituto de Fitosanidad del Colegio de Posgraduados; además, se utilizaron 23 cepas de hongos fitopatógenos (Tabla 1) para su comparación macroscópica sobre la producción de glomérulos en medio de cultivo sólido, las cuales provenían del cepario de hongos del Laboratorio de Alta Tecnología de Xalapa de la Universidad Veracruzana (LATEX-UV); dichas cepas fueron aisladas de diferentes cultivos e identificadas en función de sus características morfológicas y de claves dicotómicas (Barnett y Barry, 1998). Todos los hongos fitopatógenos en estudio fueron sembrados y mantenidos en cajas Petri con medio de papa-dextrosa y agar (PDA) marca DIBICO e incubados a mía temperatura constante de 25 ± 2 °C.
Prueba de patogenicidad de C. gloeosporioides
Empleando la técnica de asepsia de Finlay et al. (1992), dos frutos de plátano Roatán, variedad Valery (Musa sapientum), libre de lesiones, se sumergieron en una solución 50 % v/v agua/etanol duirante 2 min y se dejó secar a flujo de aire. Posteriormente, uno de estos se inoculó con esporas de C. gloeosporioides, procedentes de mi cultivo sólido de PDA e infusión de plátano (200 g/L de fruta, 15 días, 27 °C), realizando dos incisiones de 1 cm con una aguja estéril, la primera en el extremo apical y la otra en la parte media. Tanto el fruto inoculado como el blanco se incubaron en cámara húmeda a 25 ± 2 °C. Para re-aislar el hongo se tomaron diariamente muestras del fruto durante 10 días y se sembraron en cajas con PDA incubando por 7 días a 25 ± 2°C. Finalmente, dichos aislamientos se observaron macro y microscópicamente para identificarlos mediante claves dicotómicas (Barnett y Barry, 1998).
Evaluación macroscópica de glomérulos grasos en hongos microscópicos
La cepa de C. gloeosporioides junto con las 23 cepas de hongos fitopatógenos, fueron cultivadas en cajas Petri con PDA durante 10 días a 27 °C. Concluido ese periodo, se tomaron muestras para ser observadas macro y microscópicamente en búsqueda de formación masiva de glomérulos grasos.
Cultivo masivo de C. gloeosporioides
Un total de 14 L fueron cultivados en matraces Erlenmeyer de 500 mL, conteniendo 100 mL de un medio de infusión de plátano (200 g/L de plátano Roatán variedad Valery), inoculados con una suspensión de 1 X 107 esporas/mL de C. gloeosporioides, los cuales fueron mantenidos en agitación constante de 150 rpm y a una temperatura de 25 ± 2 °C durante 15 días (Trigos et al., 1997).
Extracción y purificación de compuestos
El caldo de fermentación fue filtrado a través de papel filtro (Whatman No. 42) y con ello la biomasa producida fue separada y extraída exhaustivamente con acetato de etilo. El caldo de cultivo resultante se extrajo en un equipo de extracción líquido-líquido, utilizando cloroformo como único disolvente; posteriormente, éste fue eliminado bajo presión reducida y ambos extractos fueron purificados mediante cromatografía en columna, utilizando como fase estacionaria gel de sílice 60 (Merck 0.040-0.063 mm). Las columnas fueron eluídas con hexano y mezclas de hexano-acetato de etilo en gradiente ascendente de polaridad. Para monitorear la separación de los compuestos, se utilizó cromatografía de capa delgada (CCD) de gel de sílice (Merck 60 GF254 de 0.2 mm de grosor).
Aislamiento de compuestos
De la fracción hexánica del extracto clorofórmico de caldo de cultivo se obtuvieron 5.89 g de un sólido blanco con P.f. 39-44 °C, que se reveló bajo luz UV a 365 nm y presentó un Rf= 0.6 (Hexano:Acetato de Etilo 9:1) y se denominó compuesto 1. Posteriormente, de las fracciones de 8:2 Hexano:Acetato de etilo, del extracto etíl-acético, se obtuvieron 20 mg de un sólido cristalino blanco con P.f. 155-158 °C, tras revelar con vapores de iodo, presentó un Rf= 0.72 (Hexano:Acetato de Etilo 7:3) y se denominó compuesto 2.
Esterificación de los ácidos grasos
Los ésteres metílicos se prepararon de acuerdo con el método de Stahl y Klug (1996), usando BF3 en metanol a 14 %. La extracción de éstos se realizó utilizando 1.0 mL de hexano grado HPLC; posteriormente, el extracto hexánico se secó con Na2SO4, se filtró y se inyectó en el cromatógrafo de gases acoplado a un espectrómeto de gases como se indica.
Perfil de ácidos grasos
Los compuestos fueron separados utilizando un cromatógrafo de gases Agilent Technologies modelo 6890N, equipado con una columna DB-5 5%-fenil-metil polisiloxano (Agilent Technologies), 60 m de largo con un diámetro interno de 0.25 mm y 0.25 m de espesor de película, con el siguiente programa de temperatura: se mantuvo a 150 °C durante 5 min; posteriormente, se calentó a 210 °C a 30 °C/min, de 210 °C hasta 213 °C a 1 °C/min y de 213 °C a 225 °C a 20 °C/min y finalmente, se mantuvo a 225 °C durante 40 min, usando helio como gas acarreador a una presión de 24.91 kPa. La temperatura del inyector fue 250 °C, con una relación de división de inyección de 50:1.
Técnicas generales
Los puntos de fusión fueron determinados en un aparato Electrothermal IA9000 Series/91000 y no fueron corregidos. Los espectros de resonancia magnética nuclear (RMN) 1H y 13C se realizaron a 300 y 75 MHz respectivamente, en un espectrómetro Varian, modelo Gemini 2000, utilizando como disolvente cloroformo deuterado y como referencia interna tetrametilsilano. Los desplazamientos químicos de los espectros se dan en partes por millón (ppm) y los valores de J en Hertz (Hz). Los espectros de CG-MS fueron desarrollados en un cromatógrafo acoplado a masas Hewlett Packard G1800B a 70 eV utilizando el método de ionización directa, previa derivatización con trifluoruro de boro de la muestra apolar, utilizando estándares FAME-MIX (37 metil ésteres de ácidos grasos marca Supelco) y comparando con una base de datos (NIST MS CHEMSTATION LIBRARY, versión 1995).
Resultados
De la evaluación macroscópica de glomérulos grasos producidos por las cepas fúngicas en estudio, sólo C. gloeosporioides presentó la capacidad de producir dichos glomérulos en PDA (Figura 1) en comparación con las 23 cepas fúngicas mencionadas, por lo que se mantuvo en cajas Petri con PDA y agar con infusión de plátano a 25 + 2 °C. Posteriormente, se utilizó este medio de cultivo para comprobar que, a partir del hospedero principal del que fue aislado C. gloeosporioides, éste seguía produciendo los glomérulos de grasa observados macroscópicamente en medio PDA (Figura 2).

Como se comentó, C. gloeosporioides fue la única cepa en la que se observó la producción de glomérulos de apariencia grasa, por lo que la estrategia de purificación se orientó hacia las fracciones no polares; así, a partir del extracto clorofórmico del caldo de cultivo y de la fracción eluída con hexano, se obtuvieron 5.89 g de un sólido blanco con P.f. 39-44 °C, que reveló bajo luz UV a 365 nm y presentó un Rf=0.6 al ser eluído en un sistema de disolventes Hexano:Acetato de Etilo 9:1, que éste sólido resultó ser una mezcla de ácidos grasos de acuerdo con sus datos espectroscópicos y que denominamos como compuesto 1. De esta manera, el espectro de resonancia magnética nuclear de protón (RMN1H) muestra una serie de señales complejas a 5.35, 2.77, 2.34, 2.02, 1.63, 1.25 y 0.87 ppm, características para este tipo de compuestos, por lo que se procedió a derivatizar y analizar mediante cromatografía de gases acoplada a espectrometría de masas (CG-MS), con lo cual se identificaron los componentes como ácidos palmítico, oleico, esteárico y linoléico en una proporción de 40.1,35.2, 18.8 y 5.9 % respectivamente. Posteriormente, de las fracciones obtenidas con 8:2 hexano:acetato de etilo, del extracto etíl-acético, se obtuvo el compuesto 2, el cual es sensible a la luz y cuyos datos espectroscópicos de RMN1H y comparación contra muestra auténtica, indicaron que se trataba de ergosterol (Trigos y Ortega-Regules, 2002).
Discusión
Existen reportes de que la producción de ácidos grasos saturados e insaturados son sintetizados por hongos microscópicos, teniendo como sustrato grandes cantidades de carbohidratos (fuente de carbono), especialmente cuando los cultivos son mantenidos en medios aireados y con bajo contenido de nitrógeno (Dembitsky et al., 1992; Kahlos, 1996). En este trabajo, el medio de cultivo utilizado de infusión de plátano, presenta alta concentración de carbohidratos en comparación con el contenido de proteínas como fuente de nitrógeno, por lo que la producción de ácidos grasos fue acorde a este hecho. Sin embargo, existen varios estudios en hongos filamentosos, que demuestran el papel de los ácidos grasos insaturados (18:1, 18:2) en el desarrollo, especialmente en lo que respecta a la formación de esporas asexuales y sexuales. Por ejemplo, Aspergillus nidulans produce oxilipinas, sustancias derivadas de los ácidos oleico y linoleico, llamados factores psi (precocious sexual inducer); estas moléculas funcionan como hormonas, ya que marcan el inicio y el balance del desarrollo asexual y sexual (Champe et al, 1987; Champe y El-Zayat, 1989; Calvo et al, 2001, 2002). Con relación a lo anterior, se tiene evidencia de que los ácidos grasos de las plantas funcionan como factores inductores de la esporulación en especies de Aspergillus y, por tanto, propician la invasión del hongo al hospedero. De igual forma, se ha encontrado que el ácido linoleico tiene efectos esporogénicos en otras especies fitopatógenas como Alternaria tomato (Hyeon, 1976) y Sclerotinia fructicola (Katayama y Marumo, 1978). Por otro lado, existe también una relación entre los ácidos grasos de las plantas hospedero y los mecanismos de activación de genes que controlan la producción de sustancias esporogénicas y factores de virulencia por parte de hongos fitopatógenos (Burow et al., 1997). En este sentido, los ácidos grasos presentes en las semillas y la superficie de la mayoría de frutos son principalmente ácido linoleico, oleico y palmítico, los cuales son aprovechados por los hongos fitopatógenos, utilizando enzimas endógenas, del metabolismo de lípidos y oxilipinas para colonizar con éxito al hospedero, reproducirse, y sintetizar toxinas (Christensen y Kolomiets, 2011). De esta manera, en etapas iniciales de la infección, las esporas de hongos fitopatógenos se encuentran sobre la superficie de la planta bajo condiciones limitadas, y por lo tanto los procesos celulares relacionados con las infecciones, deben ser promovidos a través del metabolismo de los compuestos de almacenamiento (Kimura et al., 2001). Kubo y Furusawa (1991) y Asakura et al. (2012), reportaron que varias especies del género Colletotrichum forman apresorios pigmentados que en sus etapas prematuras contienen abundantes lípidos melanizados (gotas) y que a medida que el apresorio madura desaparece dicha abundancia de lípidos, debido a la lipólisis que se da en el interior del mismo. Este hecho sugiere la importancia de la degradación de lípidos que genera ácidos grasos y glicerina, requerida para generar melanina a partir de la ruta de los policétidos, la cual es necesaria para la infección e invasión del huésped mediada por los apresorios (Asakura et al, 2006).
La presencia de una concentración alta de ácidos grasos puede ser considerada como un posible papel en la patogenicidad de éste y otros géneros de hongos. En conclusión, muchos hongos fitopatógenos son capaces de alterar su morfología para infectar determinadas células y con ello penetrar y crecer (formación de haustorios) dentro de los tejidos vegetales; esta diferenciación parece estar estrechamente controlada por las señales del medio ambiente del hospedero (Xu y Hamer, 1996; Dean 1997; Kronstad et al., 1998; Lee et al., 2003). Por lo tanto, la identificación de dichas señales y las vías necesarias para su reconocimiento es un reto importante en la patogénesis fúngica. Adicionalmente, es posible que los ácidos grasos presentes en el huésped sean los responsables de la respuesta al crecimiento filamentoso y que muestren especificidad debido a las diferencias en su estado de saturación y longitud de la cadena de carbonos (Klose et al., 2004), logrando con ello un éxito en la colonización del hospedero. Finalmente, la producción elevada de ácidos grasos in vitro, así como en el fruto por C. gloeosporioides abre la posibilidad de que esta especie sea capaz de producir masivamente ácidos grasos como estrategia no selectiva de invasión y penetración o simplemente como una característica evolutiva del género que puede ser de utilidad para su identificación en campo.
Agradecimientos
Los autores agradecen a los Doctores Remedios Mendoza y Oscar García de la Unidad de Servicios de Apoyo de Resolución Analítica (SARA) de la Universidad Veracruzana por el soporte instrumental, así como por el financiamiento al CONACYT a través del proyecto de Ciencia Básica: 181820 y al apoyo otorgado por la SEP: Fortalecimiento de cuerpos académicos (UVCA:354).
Literatura citada
Asakura, M., T. Okuno, Y. Takano, 2006. Multiple contributions of peroxisomal metabolic function to fungal pathogenicity in Colletotrichum lagenarium. Applied Environmental Microbiology 72:6345-6354. [ Links ]
Asakura, M., K. Yoshino, A.M. Hill, Y. Kubo, Y. Sakai, Y. Takano, 2012. Primary and secondary metabolism regulates lipolysis in appressoria of Colletotrichum orbiculare. Fungal Genetics and Biology 49:967-975. [ Links ]
Barnett, H.L., B.H. Barry, 1998. Ilustrated genera of imperfect fungi. Fourth edition, APS Press, St. Paul Minnesota. [ Links ]
Burow, G.B., T.C. Nesbitt, J. Dunlap, N.P. Keller, 1997. Seed lipoxygenase products modulate Aspergillus mycotoxin biosynthesis. Molecular Plant-Microbe Interactions 10:380-387. [ Links ]
Calvo, A.M., H.W. Gardne, N.P. Keller, 2001. Genetic connection between fatty acid metabolism and sporulation in Aspergillus nidulans. The Journal of Biological Chemistry 276:25166-2511 A. [ Links ]
Calvo, A., A.R. Wilson, J.B. Woo, P. Keller, 2002. Relationship between secondary metabolism and fungal development. Microbiology and molecular Biology Reviews 66:447-459. [ Links ]
Champe, S.P., P. Rao, A. Chang, 1987. An endogenous inducer of sexual development in Aspergillus nidulans. Journal of General Microbiology 133:1383-1388. [ Links ]
Champe, S.P., A.A. E. El-Zayat, 1989. Isolation of a sexual sporulation hormone from Aspergillus nidulans. Journal of Bacteriology 171: 3982-3988. [ Links ]
Christensen, S.A., M.V. Kolomiets, 2011. The lipid language of plant-fungal interactions. Fungal Genetics and Biology 48:4-14. [ Links ]
Dean, R.A., 1997. Signal pathways and appressorium morphogenesis. Annual Review of Phytopathology 35:211-234. [ Links ]
Dembitsky,V.M.,E.E. Shubina,A.Kashin, 1992. Phospholipid and fatty acid composition of some Basidiomycetes. Phytochemistry 31: 845-849. [ Links ]
Finlay, A.R., C. Lubin, A.E. Brown, 1992. The banana stall as a source of inoculum of fungal pathogens which cause crown rot. Tropical Scientia 32:343-352. [ Links ]
Garcia-Pajon, CM., I. Collado, 2003. Secondary metabolites isolated from Colletotrichum species. Natural Products Report 20:426-431. [ Links ]
Gohbara, M., Y. Kosuge, S. Yamasaki, Y. Kimura, A. Suzuki, S. Tamura, 1978. Isolation, structures and biological activities of colletotrichins, phytotoxic substances from Colletotrichum nicotianae. Agricultural and Biologycal Chemistry 42:1037-1043. [ Links ]
Hyeon, B., 1976. Chemical studies on the factors controlling sporulation of fungi. Chemical Regultions of Plants 11:69-76. [ Links ]
Jayasankar, S., R. Litz, D.J. Cray, P. Moon, 1999. Responses of embriogenic mango cultures and seedlings to bioassays to a partially purified phytotoxin produced by a mango leaf isolate of Colletotrichum gloeosporioides Penz. In Vitro Cellular and Developmental Biology-Plant35:475-479. [ Links ]
Jayashinghe, C.K., T.H. Fernando, 2001. Toxic activity from liquid culture of Colletotrichum acutatum. Mycopathologia 152:97-101. [ Links ]
Jeffries, P., J.C. Dodd, M.J. Jeger, RA. Plumbley, 1990. The biology and control of Colletotrichum species on tropical fruit crops. Plant Pathology 39:343-366. [ Links ]
Jeger, M., S. Eden-Green, A. Johanson, J. Waller, A. Brown, 1995. Banana diseases. In: Gowen (ed) Banana and plantains. Chapman and Hall, Londres. [ Links ]
Kahlos, K, 1996. The characterization of some lipid metabolites of Gloeophyllum odoratum grown in vitro. Mycological Research 100:23-26. [ Links ]
Katayama, M., S. Marumo, 1978. R(2)-glycerol monolinoleate, a minor sporogenic substance of Sclerotinia fructicola. Agricultural and Biological Chemistry 42:1431-1433. [ Links ]
Kimura, A., Y. Takano, I. Furusawa, T. Okuno, 2001. Peroxisomal metabolic function is required for appressorium-mediated plant infection by Colletotrichum lagenarium. Plant Cell 13:1945-1957. [ Links ]
Klose, J., M. Moniz De Sá, J.W. Kronstad, 2004. Lipid-induced filamentous growth in Ustilago maydis. Molecular Microbiology 52:823-835. [ Links ]
Kronstad J., D. Maria, A.D. Funnell, D. Laidlaw, R.D. Lee, N., M.M. de Sa, M. Ramesh, 1998. Signaling via cAMP in fungi: interconnections with mitogen-activated protein kinase pathways. Archives of Microbiology 170:395-404. [ Links ]
Kubo, Y, I. Furusawa, 1991. Melanin biosynthesis: prerequisite for successful invasion of the plant host by appressoria of Colletotrichum and Pyricularia. In: Cole, G.T., H.C. Hoch (Eds.), The Fungal Spore and Disease Initiation in Plants and Animals. Plenum Publishing, New York. pp. 205-217. [ Links ]
La Camera, S., G. Gouzerh, S. Dhondt, L. Hoffmann, B. Fritig, M. Legrand, T. Heitz, 2004. Metabolic reprogramming in plant innate immunity: the contributions of phenylpropanoid and oxylipin pathways. Immunological Reviews 198:267-284. [ Links ]
Lee, N, C.A. D'Souza, J.W. Kronstad, 2003. Of smuts, blasts, mildews, and blights: cAMP signaling in phytopathogenic fungi. Annual Review of Phytopathology 41:399-427. [ Links ]
Lima, R., S. Oliveira, M. Menezes, 2003. Caracterização enzimática e patogenicidad cruzada de Colletotríchum spp., associados a doenças de pós-colheita. Fitopatología Brasileira 28:620-625. [ Links ]
Noverr, M.C., J.R. Erb-Downward, G.B. Huffhagle, 2003. Production of eicosanoids and other oxylipins by pathogenic eukaryotic microbes. Clinical Microbiology Reviews 16:517-533. [ Links ]
Peres, N, E. Kurumae, M. Dias, N. De Souza, 2002. Identification and characterization of Colletotrichum spp., affecting fruit after harvest in Brazil. Journal of Phytopathology 150:128-134. [ Links ]
Raut, S., S. Ranade,2004. Diseases of banana and their management. Disease of Fruits and Vegetables 2:37-57. [ Links ]
Singh, A., M. Del Poeta, 2011. Lipid signalling in pathogenic fungi. Cellular Microbiology. 13:177-185. [ Links ]
Stahl P.D., M.J. Klug, 1996. Characterization and differentiation of filamentous fungi based on fatty acid composition. Applied Environmental Microbiology 62:4136-4146. [ Links ]
Trigos, Á., S. Reyna, M.L. Gutiérrez, M. Sanchez, 1997. Diketopiperazines from cultures of the fungus Colletotrichum gloesporoides. Natural Products Letters 11:13-16. [ Links ]
Trigos, Á., A. Ortega-Regules, 2002. Selective destruction of microscopic fungi through photo-oxidation of ergosterol. Mycologia 94: 563-568. [ Links ]
Xu, J.R., J.E. Hamer, 1996. MAP kinase and cAMP signaling regulate infection structure formation and pathogenic growth in the rice blast fungus Magnaporthe grísea. Genes and Development 10: 2696-2. [ Links ]














